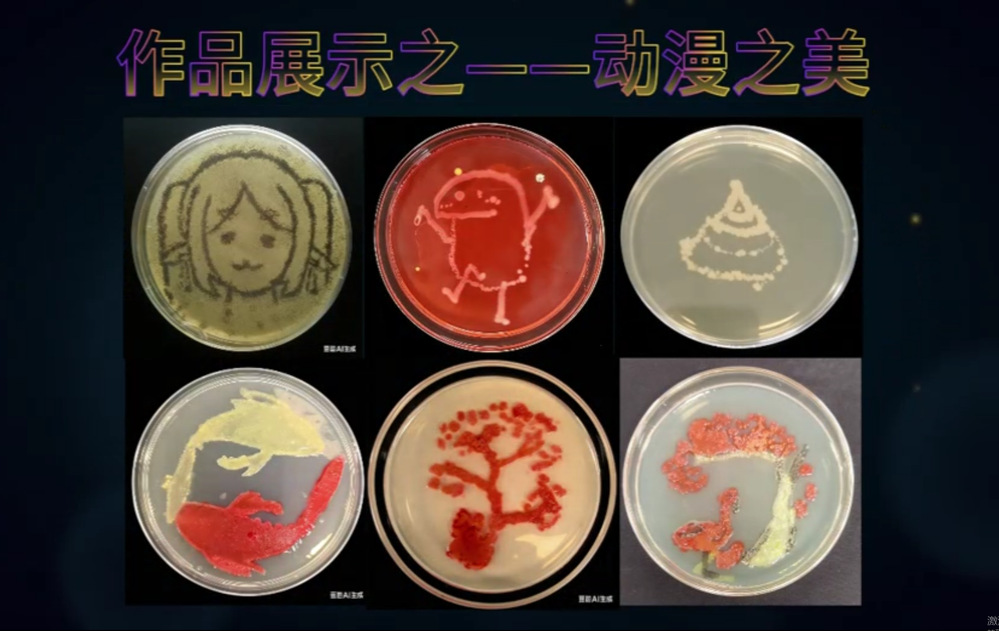

12月30日,我校召开“大中小一体化”科学教育项目实践推进暨新项目申报会。党总支书记、校长汤胜,校长助理戈益超听取相关汇报,会议由科学实践中心负责人李明芳主持。

余飞老师汇报《科学影像创作与实践》项目的课程开展情况。她带领学生探索科学现象、开展探究学习,系统传授影像拍摄与技术处理技能,并现场放映科学微电影《破解“暗角”密码:校园节能环保计划》,获得与会老师一致好评。王晨曦老师汇报《智能光伏微电网》项目的阶段性成果,详细介绍了学生参与光伏电路组建课程学习、调试光伏板追光电路模型的制作与使用情况。同时,他带来“24V低压光伏-充放电模型”和“红外光控路灯-自动照明模型”展示盒,直观易懂、操作简便。
![]() | ![]() |

娄志义老师通过视频展示《微观宇宙的瑰丽画卷——微生物作画》项目进展。微观世界蕴藏无限奥秘,学生以微生物为“画笔”,勾勒出“叶之美”“动漫之美”及栩栩如生的十二生肖作品,既展现了微观世界的神奇美妙,也凸显了科学教育的趣味性与创新性。王芝老师汇报《基于无土栽培技术的常见蔬菜智能种植》项目,她带领学生实现种植品种多样化、实践维度纵深化、项目过程探究化,聚焦课程体系化建设,拓展课程范围,深化实践与理论的融合,推动教学与科学实践协同发展。
![]() | ![]() |

随后,三位老师依次进行新项目申报。周军华老师申报《“观云测天,探索自然”气象科学实践教育基地建设项目》,计划打造集观测、记录、学习、展示于一体的校园气象科学实践平台,为学生搭建亲近科学、了解自然的窗口。刘红蕾老师申报《珍藏生命:植物与昆虫标本采集与制作项目》,期望通过植物与昆虫标本制作,培养学生的观察、操作能力,激发其创造力与艺术审美,引导学生走进自然、热爱自然,在实践中探寻生物世界的奥秘。梁辉老师申报《人脸识别简单交互机器人》项目。在人工智能、物联网等前沿科技迅猛发展的背景下,中小学开设智能硬件课程是基础教育向“核心素养导向”转型的重要探索。初中生从零搭建机器人,是跨学科知识的高阶整合与应用,集中体现了科技与创新,更是培养学生工程思维、创新能力的优质载体。
![]() | ![]() | ![]() |
与会领导对项目的阶段性成果给予高度评价,并针对性提出指导建议。戈益超提出,科学教育实践项目要打造特色品牌,完善课程设置,形成体系化教学模式,注重成果收集、展示与推广。
汤胜表示,我校长期聚焦科普教育、科学实践与科技创新三大方向的规划发展,在科学教育领域具备独特优势。在近一年的科学实践项目推进过程中,学生参与积极性高涨,已取得良好实效。他希望科学实践中心发掘更多优质新项目,使教师依托现有平台与师资力量,充分保障学生在科学实践中的主导作用,让更多学生在科学实践中收获成长与进步。
科学实践项目是点燃学生科学梦想、提升科学素养的关键抓手。学校将持续支持各类项目开展,推动“大中小一体化”科学教育体系不断完善,为培养更多具备科学素养、创新精神与实践能力的人才而不懈努力!
供稿:科学实践中心 李明芳
一审:赵子君
二审:蒋克兢
三审:黄乃斌








